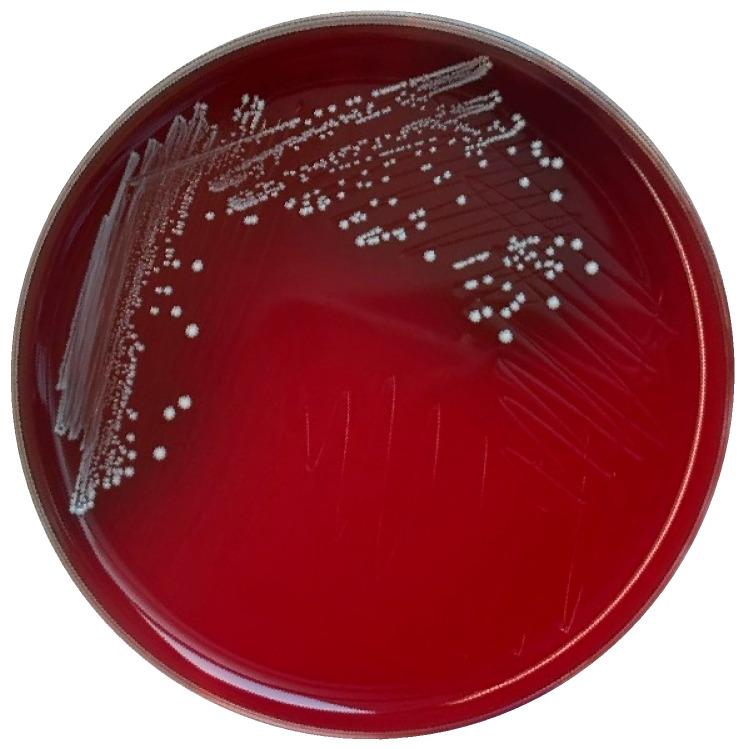
https://cdn.ncbi.nlm.nih.gov/pmc/blobs/e3ad/12189428/43dcd321a619/antibiotics-14-00612-g001.jpg

从山羊粪便中分离出的RB10的基因组特征及安全性评估
Genomic Characterization and Safety Evaluation of RB10 Isolated from Goat Feces.
作者信息
Chaichana Nattarika, Suwannasin Sirikan, Boonsan Jirasa, Yaikhan Thunchanok, Klaysubun Chollachai, Singkhamanan Kamonnut, Wonglapsuwan Monwadee, Pomwised Rattanaruji, Konglue Siriwimon, Chema Rusneeta, Saivaew Manaschanan, Surachat Komwit
机构信息
Department of Biomedical Sciences and Biomedical Engineering, Faculty of Medicine, Prince of Songkla University, Hat Yai 90110, Songkhla, Thailand.
Division of Biological Science, Faculty of Science, Prince of Songkla University, Hat Yai 90110, Songkhla, Thailand.
出版信息
Antibiotics (Basel). 2025 Jun 16;14(6):612. doi: 10.3390/antibiotics14060612.
The genus includes a diverse group of bacteria that are commonly found in the gastrointestinal tracts of humans and animals, as well as in various environmental habitats. In this study, RB10, isolated from goat feces, was subjected to comprehensive genomic and functional analysis to assess its safety and potential as a probiotic strain. The genome of RB10, with a size of 2,713,772 bp and a GC content of 38.3%, was assembled using Oxford Nanopore Technologies (ONT). Genome annotation revealed 3375 coding sequences (CDSs) and highlighted key metabolic pathways involved in carbohydrate, protein, and amino acid metabolism. The strain was susceptible to important antibiotics, including ampicillin, chloramphenicol, tetracycline, and vancomycin, but exhibited resistance to aminoglycosides, a common trait in species with non-hemolytic activity. Genomic analysis further identified two intrinsic antimicrobial resistance genes (ARGs). The strain also demonstrated antimicrobial activity against DMST 11098 and Typhi DMST 22842, indicating pathogen-specific effects. Key genes for adhesion, biofilm formation, and stress tolerance were also identified, suggesting that RB10 could potentially colonize the gut and compete with pathogens. Moreover, the presence of bacteriocin and secondary metabolite biosynthetic gene clusters suggests its potential for further evaluation as a biocontrol agent and gut health promoter. However, it is important to note that RB10 was isolated from goat feces, a source that may harbor both commensal and opportunistic bacteria, and therefore additional safety assessments are necessary. While further validation is needed, RB10 exhibits promising probiotic properties with low pathogenic risk, supporting its potential use in food and health applications.
该属包括一组多样的细菌,它们常见于人类和动物的胃肠道以及各种环境栖息地中。在本研究中,从山羊粪便中分离出的RB10菌株接受了全面的基因组和功能分析,以评估其作为益生菌菌株的安全性和潜力。RB10的基因组大小为2,713,772 bp,GC含量为38.3%,使用牛津纳米孔技术(ONT)进行组装。基因组注释揭示了3375个编码序列(CDS),并突出了参与碳水化合物、蛋白质和氨基酸代谢的关键代谢途径。该菌株对包括氨苄青霉素、氯霉素、四环素和万古霉素在内的重要抗生素敏感,但对氨基糖苷类抗生素表现出抗性,这是具有非溶血活性的该属物种的常见特征。基因组分析进一步鉴定出两个内在抗微生物抗性基因(ARG)。该菌株还对DMST 11098和伤寒杆菌DMST 22842表现出抗菌活性,表明具有病原体特异性作用。还鉴定出了参与黏附、生物膜形成和应激耐受的关键基因,这表明RB10可能有潜力在肠道中定殖并与病原体竞争。此外,细菌素和次生代谢物生物合成基因簇的存在表明其作为生物防治剂和肠道健康促进剂具有进一步评估的潜力。然而,需要注意的是,RB10是从山羊粪便中分离出来的,而山羊粪便可能同时含有共生菌和机会致病菌,因此需要进行额外的安全性评估。虽然需要进一步验证,但RB10表现出有前景的益生菌特性,致病风险较低,支持其在食品和健康应用中的潜在用途。